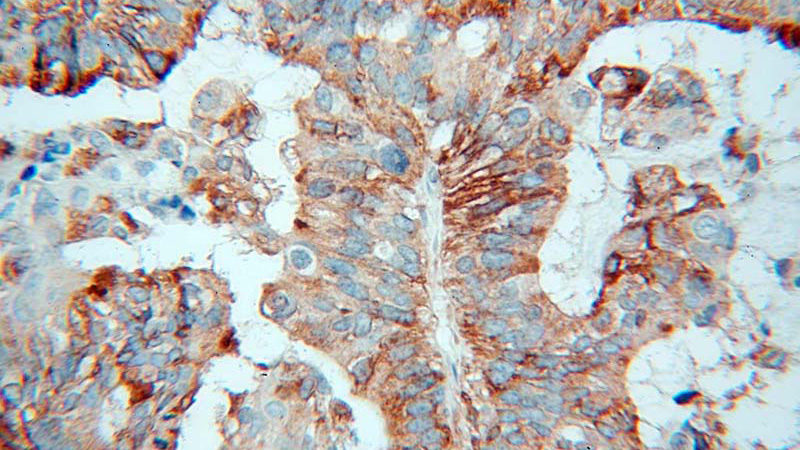
Immunohistochemical of paraffin-embedded human ovary tumor using Catalog No:108206(ERAP1 antibody) at dilution of 1:100 (under 40x lens)
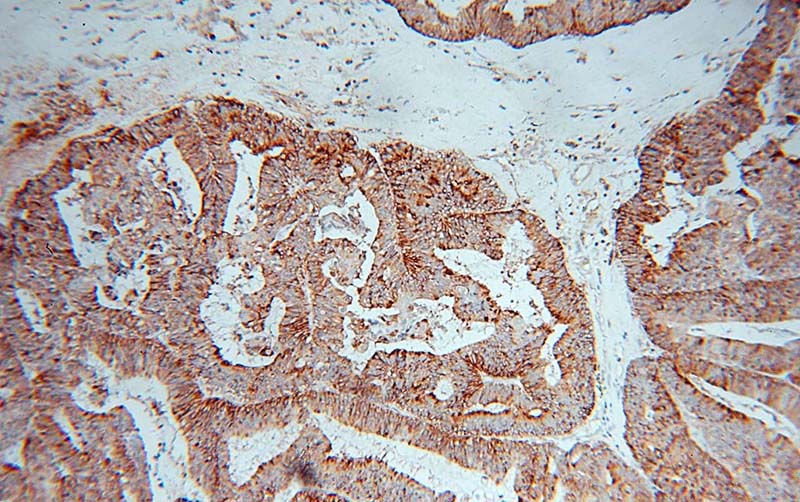
Immunohistochemical of paraffin-embedded human ovary tumor using Catalog No:108206(ERAP1 antibody) at dilution of 1:100 (under 10x lens)

-
Product Name
ARTS1 antibody
- Documents
-
Description
ARTS1 Rabbit Polyclonal antibody. Positive WB detected in Jurkat cells. Positive IP detected in Jurkat cells. Positive IHC detected in human ovary tumor tissue. Observed molecular weight by Western-blot: 106 kDa
-
Tested applications
ELISA, WB, IHC, IP
-
Species reactivity
Human,Mouse,Rat; other species not tested.
-
Alternative names
A LAP antibody; ALAP antibody; Aminopeptidase PILS antibody; APPILS antibody; ARTS 1 antibody; ARTS1 antibody; ERAAP antibody; ERAAP1 antibody; ERAP1 antibody; KIAA0525 antibody; PILS AP antibody; PILSAP antibody
-
Isotype
Rabbit IgG
-
Preparation
This antibody was obtained by immunization of ARTS1 recombinant protein (Accession Number: NM_001198541). Purification method: Antigen affinity purified.
-
Clonality
Polyclonal
-
Formulation
PBS with 0.02% sodium azide and 50% glycerol pH 7.3.
-
Storage instructions
Store at -20℃. DO NOT ALIQUOT
-
Applications
Recommended Dilution:
WB: 1:500-1:5000
IP: 1:200-1:2000
IHC: 1:20-1:200
-
Validations

Jurkat cells were subjected to SDS PAGE followed by western blot with Catalog No:108206(ERAP1 antibody) at dilution of 1:1000
Immunohistochemical of paraffin-embedded human ovary tumor using Catalog No:108206(ERAP1 antibody) at dilution of 1:100 (under 40x lens)
Immunohistochemical of paraffin-embedded human ovary tumor using Catalog No:108206(ERAP1 antibody) at dilution of 1:100 (under 10x lens)

IP Result of anti-ERAP1 (IP:Catalog No:108206, 4ug; Detection:Catalog No:108206 1:600) with Jurkat cells lysate 3600ug.
-
Background
ARTS1 is a 100 kDa, monomeric, soluble zinc aminopeptidase that belongs to the M1 family of metallo-peptidases. ERAP1 is induced by interferon-gama and can degrade peptides 9-15 residues long(PMID:18987748).It can be glycosylated to 120KDa and form homodimers and heterodimers(PMID:15908954).
-
References
- Seregin SS, Rastall DP, Evnouchidou I. Endoplasmic reticulum aminopeptidase-1 alleles associated with increased risk of ankylosing spondylitis reduce HLA-B27 mediated presentation of multiple antigens. Autoimmunity. 46(8):497-508. 2013.
- Evnouchidou I, Weimershaus M, Saveanu L, van Endert P. ERAP1-ERAP2 dimerization increases peptide-trimming efficiency. Journal of immunology (Baltimore, Md. : 1950). 193(2):901-8. 2014.
Related Products / Services
Please note: All products are "FOR RESEARCH USE ONLY AND ARE NOT INTENDED FOR DIAGNOSTIC OR THERAPEUTIC USE"
